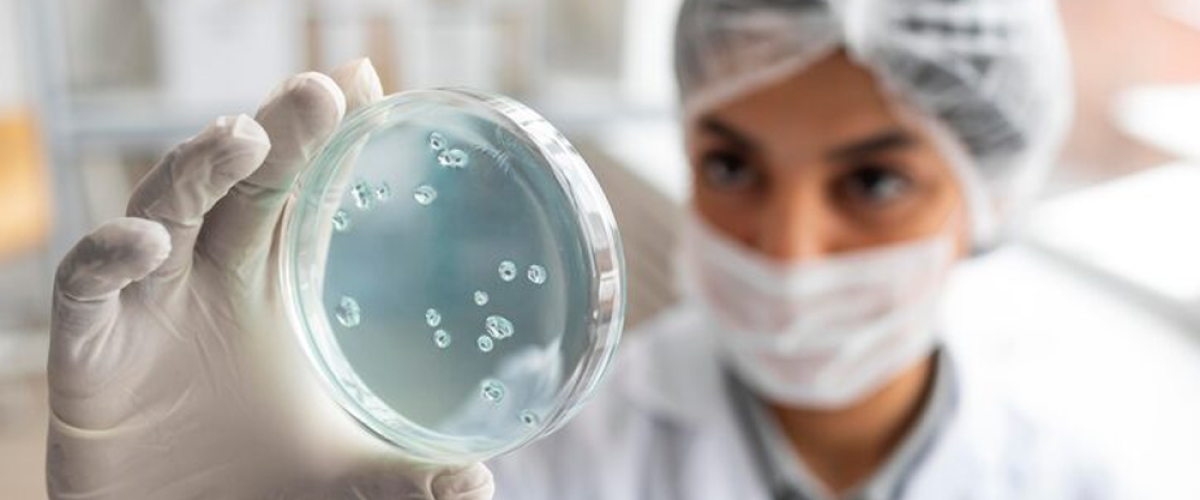
Stem Cell Therapy

A regenerative medicine technique called stem cell treatment replaces or repairs damaged tissues and organs by using undifferentiated cells. With their capacity to self-renew and differentiate into distinct cell types, stem cells may one day be used to treat a wide range of illnesses.
Stem cell types used in therapy include:
1. ESCs or embryonic stem cells
- Derived from blastocysts, which are early-stage embryos.
- Any cell type can be produced by a pluripotent organism.
- Use is restricted by ethical issues.
2. Somatic Adult Stem Cells
- Found in blood, fat, and bone marrow, among other tissues.
- Multipotent (limited capacity for differentiation).
- Hematopoietic stem cells, for instance, are utilized in bone marrow transplants.
3. Induced Pluripotent Stem Cells (iPSCs)
- ESC-like behaviour was reprogrammed into adult cells.
- Avoids moral dilemmas, but if left unchecked, it can cause cancer.
4. Mesenchymal Stem Cells (MSCs)
- Separated from the umbilical cord, fat, or bone marrow.
- Utilized for tissue repair and anti-inflammatory purposes (e.g., osteoarthritis, heart disease).
Symptoms Treated or Targeted by Stem Cell Therapy
By repairing damaged tissues, stem cell treatment seeks to reduce illness symptoms. Among the examples are:
- Osteoarthritis causes inflammation and joint discomfort.
- Muscular dystrophy, or muscle weakness.
- Deterioration in cognition (neurological conditions).
- Poor wound healing (ulcers caused by diabetes).
- Loss of vision (degeneration of the retina).
Hazards and Difficulties
- Development of a tumour (if stem cells divide arbitrarily).
- Rejection by the immune system (unless autologous cells are employed).
- Ethical issues, particularly in relation to embryonic stem cells.
- Clinics with no track record (many provide unlicensed therapies).